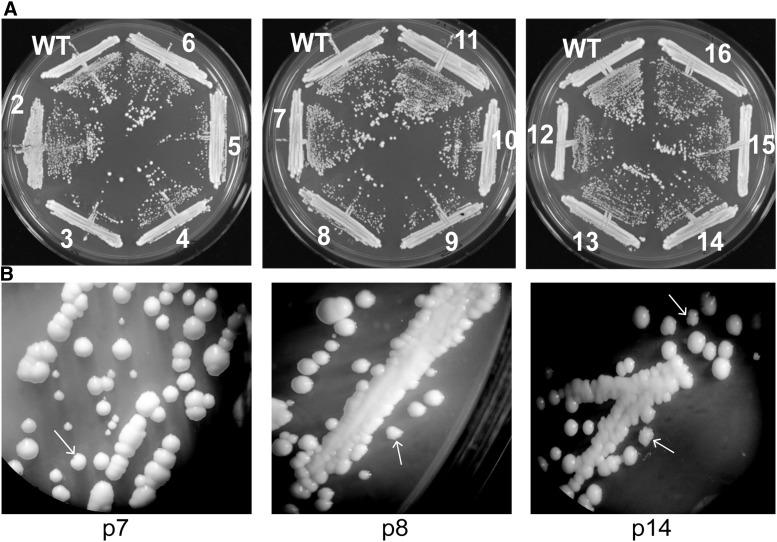
https://cdn.ncbi.nlm.nih.gov/pmc/blobs/a552/6778800/2c455ecac8c6/3345f2.jpg

酵母芽殖细胞中端粒的替代延长。
Alternative Lengthening of Telomeres in the Budding Yeast .
机构信息
Department of Biology, Genetics group, Lund University, 223 62 Lund, Sweden
Department of Biology, Genetics group, Lund University, 223 62 Lund, Sweden.
出版信息
G3 (Bethesda). 2019 Oct 7;9(10):3345-3358. doi: 10.1534/g3.119.400428.
The enzyme telomerase ensures the integrity of linear chromosomes by maintaining telomere length. As a hallmark of cancer, cell immortalization and unlimited proliferation is gained by reactivation of telomerase. However, a significant fraction of cancer cells instead uses alternative telomere lengthening mechanisms to ensure telomere function, collectively known as Alternative Lengthening of Telomeres (ALT). Although the budding yeast () has a proficient telomerase activity, we demonstrate here that telomeres in are efficiently maintained by a novel ALT mechanism after telomerase knockout. Remarkably, telomerase-negative cells proliferate indefinitely without any major growth crisis and display wild-type colony morphology. Moreover, ALT cells maintain linear chromosomes and preserve a wild-type DNA organization at the chromosome termini, including a short stretch of terminal telomeric sequence. Notably, ALT telomeres are elongated by the addition of ∼275 bp repeats containing a short telomeric sequence and the subtelomeric DNA located just internally (TelKO element). Although telomeres may be elongated by several TelKO repeats, no dramatic genome-wide amplification occurs, thus indicating that the repeat addition may be regulated. Intriguingly, a short interstitial telomeric sequence (ITS) functions as the initiation point for the addition of the TelKO element. This implies that telomeres are structurally predisposed to efficiently switch to the ALT mechanism as a response to telomerase dysfunction.
端粒酶通过维持端粒长度来确保线性染色体的完整性。作为癌症的一个标志,端粒酶的重新激活使细胞获得了永生和无限增殖。然而,相当一部分癌细胞则使用替代的端粒延长机制来确保端粒的功能,这些机制统称为端粒的替代性延长(ALT)。尽管 budding yeast () 具有高效的端粒酶活性,但我们在这里证明,在端粒酶敲除后,通过一种新的 ALT 机制有效地维持了酵母的端粒。值得注意的是,端粒酶缺失的细胞可无限期增殖,而没有任何重大的生长危机,并表现出野生型的菌落形态。此外,ALT 细胞维持线性染色体,并在染色体末端保持野生型的 DNA 组织,包括一小段短的端粒序列。值得注意的是,ALT 端粒通过添加含有短端粒序列和内部稍远的亚端粒 DNA 的约 275 bp 重复序列来延长(TelKO 元件)。尽管端粒可能通过几个 TelKO 重复序列延长,但不会发生剧烈的全基因组扩增,这表明重复序列的添加可能受到调控。有趣的是,一个短的中间端粒序列(ITS)作为添加 TelKO 元件的起始点。这意味着酵母的端粒在结构上倾向于有效地切换到 ALT 机制,以应对端粒酶功能障碍。